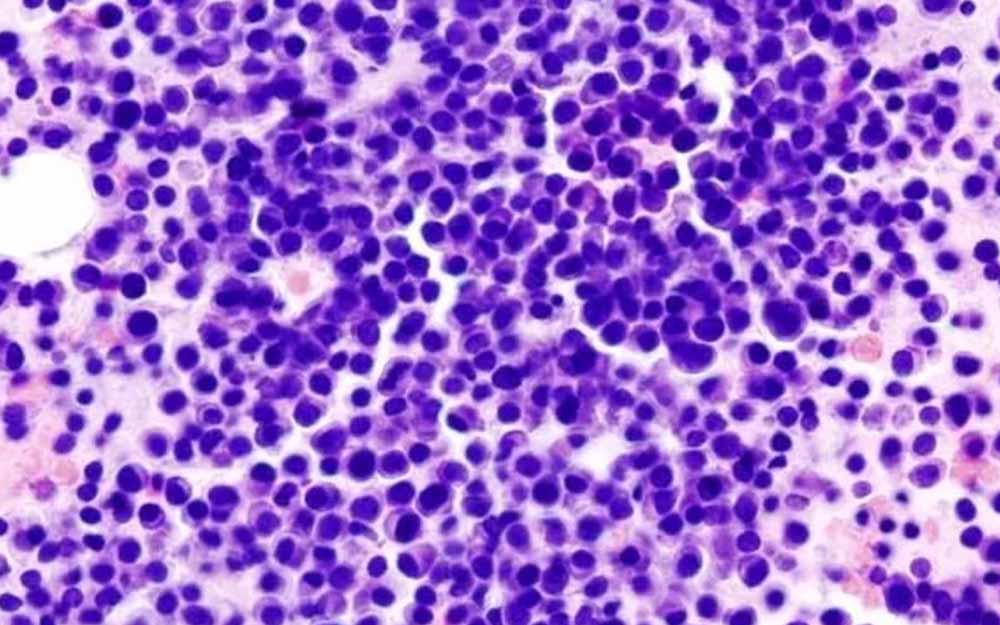

El mismo está disponible en Argentina para el tratamiento de pacientes adultos en recaída o refractario, previamente expuestos a al menos tres terapias.
El mieloma múltiple es un tipo de cáncer de la sangre poco frecuente que afecta a las células plasmáticas, una clase de glóbulos blancos que se encuentran en la médula ósea y, aunque en las últimas dos décadas el tratamiento de la enfermedad avanzó considerablemente, sigue siendo incurable y la mayoría de los pacientes se vuelven refractarios a las terapias, mientras que se estima que la sobrevida a una tercera terapia es solo del 15% de los pacientes y el tiempo en remisión disminuye con cada línea de tratamiento.
Las citadas células anormales se multiplican descontroladamente, generan anticuerpos defectuosos y afectan la producción normal de glóbulos rojos, blancos y plaquetas, desarrollando potencialmente complicaciones graves como insuficiencia renal, anemia, fracturas óseas, hipercalcemia e infecciones recurrentes.
En la Argentina, proyecciones de incidencia de mieloma múltiple permiten estimar la existencia de alrededor de 1.300 nuevos casos por año, lo que equivale en promedio a 3,5 diagnósticos cada día. La prevalencia aumenta con la edad, con un pico entre los 50 y los 70 años.
Ahora, la Administración Nacional de Medicamentos, Alimentos y Tecnología Médica (ANMAT) aprobó recientemente un nuevo medicamento para el tratamiento de pacientes adultos con mieloma múltiple en recaída o refractario, que recibieron al menos tres terapias previas.
Se trata de talquetamab, un anticuerpo biespecífico anti-GPRC5DxCD3 redireccionador de linfocitos T y el mismo representa una nueva opción terapéutica que, con un mecanismo de acción diferente, demostró un beneficio clínico significativo.
Su aprobación por la Administración de Alimentos y Medicamentos (FDA, por sus siglas en inglés) en agosto de 2023 se basa en los resultados del estudio de fase 1/2 MonumenTAL-1 que evaluó su eficacia y seguridad en más de 300 pacientes con mieloma múltiple en recaída o refractario y, según el mismo, se alcanzaron tasas de respuesta global del 74% en pacientes que no habían recibido terapias previas con redirección de linfocitos T, y de 67% en pacientes previamente expuestos a estas terapias.
Además de su eficacia, la terapia demostró una mediana de duración de la respuesta de hasta 17,5 meses, con una supervivencia global a 24 meses del 67,1% y este nuevo desarrollo de Johnson & Johnson está disponible en el país bajo condiciones de uso hospitalario para el tratamiento en monoterapia de pacientes adultos con mieloma múltiple en recaída y refractario, que recibieron al menos 3 tratamientos previos y presentaron progresión de la enfermedad al último tratamiento.
Es el primer anticuerpo biespecífico aprobado que se dirige simultáneamente a dos blancos terapéuticos: el receptor CD3 en las células T y el receptor GPRC5D, mostrando una modalidad de acción que le permite redirigir las células T del propio paciente hacia las células tumorales, desencadenando una respuesta inmune antitumoral potente.
Su administración es mediante una inyección subcutánea, está sujeta a un esquema de dosificación que incluye una fase inicial de escalado progresivo y luego una pauta quincenal. Esta modalidad permite una administración ambulatoria en muchos casos, con controles periódicos para el monitoreo de posibles efectos adversos.
De acuerdo con lo observado en los estudios clínicos, los más frecuentes incluyen alteraciones del gusto (disgeusia), sequedad bucal, pérdida de peso e infecciones, la mayoría de ellos de grado leve a moderado y transitorios, mientras que fue poco frecuente la discontinuación permanente del tratamiento a causa de las reacciones adversas.
La Dra. María Eugenia Funes, médica hematóloga del Hospital Británico Rosario, afirmó que "la incorporación de talquetamab al abanico terapéutico disponible en el país constituye un paso clave para tratar a pacientes que ya no responden a las combinaciones clásicas de medicamentos. Su mecanismo de acción y perfil de eficacia lo posicionan como una alternativa muy prometedora".
Por su parte, el Dr. Cristian Seehaus, médico hematólogo del Hospital Italiano de Buenos Aries, se expresó favorablemente, sosteniendo que “en la práctica clínica vemos con frecuencia pacientes que han agotado las opciones terapéuticas disponibles", a la vez que dijo que el nuevo medicamento brinda una nueva esperanza a los pacientes, con una vía de administración subcutánea y un perfil de seguridad que, según los estudios, es manejable en la mayoría de los casos".
“Estamos orgullosos de poder contar en la Argentina con un medicamento que representa un avance significativo para los pacientes con mieloma múltiple que ya han agotado las principales líneas terapéuticas. Esta droga ofrece una nueva posibilidad para una población que hasta ahora contaba con opciones muy limitadas. Seguimos trabajando firmemente con el compromiso de mejorar la sobrevida para los pacientes con mieloma múltiple”, afirmó el Dr. Ariel Perelsztein , director de Asuntos Médicos y Regulatorios del citado laboratorio.













